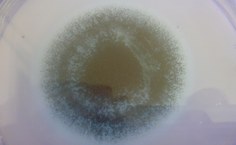
Fungo isolado de ambiente climatizado produtor de micotoxinas

Laboratório de Biologia oferece serviço de análise de qualidade do ar
Laboratório de Ambientes Climatizados do Instituto de Ciências Biológicas está capacitado para emitir laudos exigidos por lei
- Atualizado em

Lenilda Luna - jornalista
Os ambientes climatizados fazem parte do cotidiano da maioria das pessoas. Nas grandes cidades, as empresas, restaurantes, clínicas, hospitais, shoppings, áreas de lazer, hotéis, residências e vários outros espaços contam com condicionadores de ar e centrais de climatização. Mas como anda a manutenção desses equipamentos? Qual é a qualidade do ar que respiramos em locais fechados e climatizados?
Por causa de vários levantamentos feitos no Brasil, revelando que as centrais de climatização são instaladas e muitas vezes esquecidas, sem passar pela necessária limpeza e manutenção, a Vigilância Sanitária publicou, em 2003, a resolução nº 9, que estabelece padrões para o controle da qualidade do ar nestes ambientes.
Laboratório especializado
A Universidade Federal de Alagoas conta com o Laboratório de Ambientes Climatizados que oferece serviços para atender aos empresários e gestores públicos que necessitam adequar seus estabelecimentos às novas normas. O laboratório, instalado no Instituto de Ciências Biológicas e da Saúde, tem uma equipe formada por profissionais das áreas de Ciências Biológicas, Ciências Biomédicas, Química, e professores doutores em Microbiologia Aplicada e Biologia Molecular de Fungos pela Universidade Estadual de São Paulo (Unesp) e Universidade Federal de Pernambuco (UFPE)
Eurípedes Alves, doutor em Biologia de Fungos pela UFPE e professor do ICBS, explica que o laboratório está capacitado para emitir laudos com a avaliação do ambiente, analisando quantidade de fungos, concentração de gás carbônico, temperatura, umidade relativa do ar, ventilação e concentração de poeira. “São condições que devem ser controladas para evitar que o local de trabalho ou estabelecimento comercial se torne causa de doenças alérgicas e outras ameaças para a saúde coletiva”, alerta o pesquisador.
O coordenador do Laboratório de Ambientes Climatizados informa também que o trabalho realizado pela Ufal já conta com alguns parceiros, que realizam análises periódicas para manter a qualidade do ar. “São unidades hospitalares, instituições educacionais, supermercados e empresas de vários segmentos que estão atentos às normas e a necessidade de manter um ambiente saudável para os frequentadores do local”, ressalta Eurípedes Alves.
O ideal, segundo o pesquisador, é que o laudo seja emitido a cada seis meses, tanto para evitar as multas previstas na normatização, quanto para garantir a saúde coletiva, que é o mais importante, afinal, são ambientes onde boa parte dos trabalhadores passa até oito horas por dia. “Quando o ambiente está contaminado por fungos e bactérias, pode ocasionar rinites, bronquites, pneumonias, alergias e outras doenças respiratórias”, destaca o biólogo.
Os recursos obtidos pelo laboratório, que são captados pela Fundação Universitária de Desenvolvimento de Extensão e Pesquisa (Fundepes), são revertidos para fomentar pesquisas, adquirir equipamentos e contribuir com a formação de pesquisadores. “A tendência é que a fiscalização da Vigilância Sanitária nas empresas se torne cada vez mais rigorosa e é preciso capacitar profissionais para atender à demanda crescente”, diz o professor.
Estudos sobre qualidade do ar
Além de oferecer o serviço para as empresas de controle de qualidade do ar, o laboratório tem fomentado pesquisas importantes nesta área. “Temos duas teses de mestrado sobre o assunto, analisando a qualidade do ar nas salas de cirurgias e na UTI Neonatal do Hospital Universitário. Hoje quando se fala de bactérias resistentes a antibióticos, é muito importante aprofundar a pesquisa sobre essas micotoxinas”, alerta o pesquisador.
As teses e dissertações mais recentes, orientadas pelo professor Eurípedes Alves, são: “Epidemiologia molecular de beta-lactamases de espectro estendido (ESBL) e carbapenemase KPC produzidas por enterobactérias isoladas de pacientes de Alagoas”, da aluna Luana Pires; “Identificação de bactérias patogênicas isoladas na Unidade de Emergência do Agreste - AL através de PCR de amplo espectro e sequenciamento de rRNA 16S”, do aluno Daniel Gomes Coimbra; e “Avaliação do risco de infecção cruzada através das linhas d´água dos equipos odontológicos na rede pública estadual de Alagoas”, da aluna Guacyra Machado.
O grupo de pesquisa de Biologia Celular e Molecular conta ainda com a participação de cinco alunos da graduação e três de pós-graduação. “Temos várias pesquisas em andamento, que poderão servir para orientar ações de controle de riscos de contaminação em empresas públicas e privadas”, informa o professor.
Para solicitar um orçamento ao Laboratório de Ambientes Climatizados, clique aqui